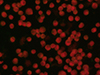
Thumbnail: Figure 3 Refer to the following caption and surrounding text.

| Issue |
Parasite
Volume 32, 2025
|
|
|---|---|---|
| Article Number | 62 | |
| Number of page(s) | 13 | |
| DOI | https://doi.org/10.1051/parasite/2025054 | |
| Published online | 25 September 2025 | |
Research Article
Evaluation of a newly developed rapid ELISA to detect anti-Ehrlichia canis antibodies in dogs
Évaluation d’un nouveau test ELISA rapide pour la détection des anticorps anti-Ehrlichia canis chez le chien
1
Agrolabo S.p.A., 10010 Scarmagno, Italy
2
Department of Veterinary Medicine and Animal Sciences, University of Milan, 26900 Lodi, Italy
* Corresponding author: This email address is being protected from spambots. You need JavaScript enabled to view it.
Received:
22
April
2025
Accepted:
1
September
2025
Abstract
Canine monocytic ehrlichiosis (CME) is a globally prevalent disease with zoonotic potential primarily caused by the obligate intracellular bacterium Ehrlichia canis, transmitted by the ticks Rhipicephalus spp. to vertebrate hosts. In dogs, CME affects immune system cells, leading to subclinical infection or acute and chronic disease forms that impact multiple organs and potentially result in death if diagnosis is delayed. Diagnosis of canine ehrlichiosis is complex, typically involving cytology, polymerase chain reaction), and serological assays such as the indirect immunofluorescence antibody test (IFAT), considered the gold standard, and enzyme-linked immunosorbent assay (ELISA). Herein, we introduce EhrlichiaCHECK Ab ELISA, a novel rapid indirect ELISA for detecting anti-E. canis antibodies in canine serum or plasma samples. The assay’s performance was validated using 112 canine samples (61 negative, 51 positive). Compared to IFAT, the ELISA exhibited high sensitivity (96.1%, 95% confidence interval [CI]: 85.4%–99.3%) and specificity (95.1%, 95% CI: 85.4%–98.7%). Furthermore, in comparison to the widely used commercial INgezim Ehrlichia ELISA (Gold Standard Diagnostics), EhrlichiaCHECK Ab ELISA demonstrated 98.0% agreement and enhanced specificity attributed to a more specific antigen, corroborated by bioinformatics analysis. The assay also demonstrated accuracy, with low percentage values of intra- and inter-assay coefficients of variation. In conclusion, our data suggest that the newly developed assay is a valuable tool for diagnosing E. canis infections in dogs.
Résumé
L’ehrlichiose monocytaire canine (EMC) est une maladie mondialement répandue à potentiel zoonotique, principalement causée par la bactérie intracellulaire obligatoire Ehrlichia canis, transmise par les tiques Rhipicephalus spp. aux hôtes vertébrés. Chez le chien, l’EMC affecte les cellules du système immunitaire, entraînant une infection subclinique ou des formes aiguës et chroniques de la maladie affectant plusieurs organes et potentiellement mortelles en cas de diagnostic tardif. Le diagnostic de l’ehrlichiose canine est complexe et implique généralement la cytologie, la réaction en chaîne par polymérase (PCR) et des tests sérologiques tels que le test d’immunofluorescence indirecte (IFAT), considéré comme la référence, et le test d’immuno-absorption enzymatique (ELISA). Nous présentons ici EhrlichiaCHECK Ab ELISA, un nouveau test ELISA indirect rapide pour la détection des anticorps anti-E. canis dans des échantillons de sérum ou de plasma canin. Les performances du test ont été validées à l’aide de 112 échantillons canins (61 négatifs, 51 positifs). Comparé à l’IFAT, l’ELISA a montré une sensibilité (96,1 %, intervalle de confiance à 95 % [IC] : 85,4 %–99,3 %) et une spécificité (95,1 %, IC à 95 % : 5,4 %–98,7 %) élevées. De plus, par rapport au test ELISA commercial INgezim Ehrlichia largement utilisé (Gold Standard Diagnostics), l’ELISA EhrlichiaCHECK Ab a démontré une concordance de 98,0 % et une spécificité améliorée attribuée à un antigène plus spécifique, corroboré par une analyse bioinformatique. Le test a également fait preuve de précision, avec de faibles valeurs en pourcentage des coefficients de variation intra- et inter-tests. En conclusion, nos données suggèrent que le test nouvellement développé est un outil précieux pour le diagnostic des infections à E. canis chez les chiens.
Key words: Ehrlichia canis / Ehrlichiosis / EhrlichiaCHECK Ab / ELISA / IFAT
Edited by: Emmanuel Liénard
© I. Ferrero et al., published by EDP Sciences, 2025
 This is an Open Access article distributed under the terms of the Creative Commons Attribution License (https://creativecommons.org/licenses/by/4.0), which permits unrestricted use, distribution, and reproduction in any medium, provided the original work is properly cited.
This is an Open Access article distributed under the terms of the Creative Commons Attribution License (https://creativecommons.org/licenses/by/4.0), which permits unrestricted use, distribution, and reproduction in any medium, provided the original work is properly cited.
Introduction
Canine monocytic ehrlichiosis (CME) is a vector-borne zoonotic disease with a global distribution. The primary vector is the tick Rhipicephalus sanguineus s.l., while mammals, including dogs, cats, and humans, serve as vertebrate hosts [7, 29, 56]. CME is mainly caused by Ehrlichia canis, although Ehrlichia chaffeensis can occasionally be involved. Both species are capable of infecting dogs and humans, leading to severe disease manifestations [9, 56]. Ehrlichia canis is an obligate intracellular Gram-negative bacterium that, after the tick takes a blood meal, localizes in the midgut and then the salivary glands of the tick. During subsequent feeding, it is transmitted to a healthy dog through the tick’s saliva. Once in the host, E. canis targets immune system cells, particularly macrophages, lymphocytes, and monocytes. Inside the cytoplasm, the bacterium differentiates and multiplies through binary fission within the phagosome, forming endosomes that take on a structure known as a “morula,” which contains numerous E. canis bacteria. Eventually, E. canis is released via exocytosis or cell lysis, allowing the infection to spread further [4].
After an incubation period of 8–20 days, depending on the Ehrlichia spp., ehrlichiosis manifests in acute, subclinical, and chronic forms that affect multiple organs and systems, including the lungs, meninges, and kidneys, and can lead to death if not diagnosed in time [4]. The acute phase typically lasts 2–4 weeks and is characterized by high fever, depression, lethargy, anorexia, lymphadenomegaly, splenomegaly, and hemorrhagic tendencies that may vanish even without chemotherapeutic treatment. In some cases, the animal may maintain the disease in a subclinical form, thus becoming an important source of infection without presenting any clinical manifestation for an extended period of months or years. During this phase, the animal appears clinically normal, with no evident signs of illness, although mild thrombocytopenia can be detected through hematological testing. Some subclinically infected dogs may progress to the chronic stage, which is the most severe and fatal form of the disease, characterized by myelosuppression and severe pancytopenia. Clinical signs are similar to those in the acute phase but more severe [4, 26]. Previous studies have identified a small group of major immunoreactive proteins in E. canis, including tandem repeat proteins (TRPs), an ankyrin repeat protein (Ank200), and the major outer membrane protein (OMP) family, which stimulate the antibody response during infection in both humans and dogs. Among the TRPs, TRP19 (or gp19), TRP36 (or gp36), TRP95, and TRP140 are all significant immunoreactive proteins [37].
The diagnosis of CME is complex. In acute cases, cytology can provide an earlier diagnosis through light microscopy by detecting typical cytoplasmic E. canis morulae in monocytes on blood smears. However, this method is considered labor-intensive and has low diagnostic sensitivity during the subclinical and chronic phases [4]. On the other hand, serological methods are valuable screening and diagnostic tools. Among these, there are the indirect immunofluorescence antibody test (IFAT), considered the gold standard, and the enzyme-linked immunosorbent assay (ELISA). However, a definitive diagnosis requires molecular techniques, such as DNA amplification by polymerase chain reaction (PCR) [26, 61]. CME can be fatal if not treated promptly and requires rapid and accurate diagnosis to initiate the most appropriate pharmacological treatment. To address this need, the R&D team of veterinary diagnostic kit supplier Agrolabo S.p.A. has developed a new ELISA test, called EhrlichiaCHECK Ab ELISA, introduced in this paper. In addition to being a rapid and qualitative assay for the detection of anti-E. canis antibodies in canine samples, it is sensitive and more specific than the previous version and commercialised tests because it is based on a novel antigen that limits cross-reactivities towards other Ehrlichia species and, therefore, reduces false-positive case detection.
Materials and methods
Ethics statement
This study did not involve human participants. Canine serum or plasma samples were collected with owner consent during routine veterinary evaluations and voluntarily donated for research purposes. The procedures performed are not considered animal experimentation and therefore are not subject to the Italian Legislative Decree 26/2014 and Directive 2019/63/EU of the European Parliament.
Samples collected in the study
A total of 112 serum or plasma samples were collected from four veterinary clinics from north and central Italy (Piedmont and Lazio regions), as well as from Greece, primarily from the Attica region. These samples were tested for anti-Ehrlichia antibodies using the gold standard method, IFAT, and were classified as negative or positive (61 negative and 51 positive), then used for all stages of test development. To ensure comprehensive representation and broad applicability of the test, no sample selection was performed. Consequently, information regarding the samples or the patients’ clinical condition was unknown. High lipemic or hemolytic samples were also included in the study. The number of samples tested is consistent with other bibliographic studies involving ELISA testing [2, 41, 52, 66].
Plate preparation and EhrlichiaCHECK Ab ELISA
Nunc PolySorp microplates (Thermo Fisher Scientific, Waltham, MA, USA) were used for test development, as they are commonly employed to immobilize both antigens [19, 55] and antibodies [49] in ELISA testing. To prepare the plates, we followed internal company protocols as well as standardized procedures [6, 17]. The microplates were coated with recombinant antigen derived from the E. canis glycoprotein gp19 (Rekom Biotech, Granada, Spain) at two concentrations, 0.5 μg/mL and 1 μg/mL, diluted in carbonate-bicarbonate (CB) buffer (pH 9.6) (Agrolabo S.p.A., Scarmagno, Italy), as previously described [17, 23]. In the final protocol, microplates were coated with 0.5 μg/mL of E. canis antigen and incubated at +2–8 °C overnight (ON). The plates were then washed, blocked with a commercial blocking solution (Surmodics, Eden Prairie, MN, USA) for 1 h at room temperature (RT), and allowed to dry at RT for 24 h before being stored at +2–8 °C.
During ELISA setup, four types of positive controls (PCs) were used, including three anti-histidine (His) tag antibodies labeled with horseradish peroxidase (HRP) of different suppliers (PC1 from Sigma-Aldrich, St. Louis, MO, USA; PC2 from Abcam Limited, Cambridge, UK; PC3 from Thermo Fisher Scientific) and one formed by a pool of canine positive sera (PC4). The negative control (NC) and samples, diluted 1:100 in a diluent formed by phosphate-buffered saline (PBS) and bovine serum albumin (BSA) (Agrolabo S.p.A.), were added in 100 μL volume in each well, followed by a 15-minute incubation at RT. After washing to remove unbound specimens, 100 μL of the conjugate anti-dog IgG antibody labeled with HRP (Bethyl Laboratories Inc., Montgomery, TX, USA) were added, followed by a 15-minute incubation at RT. After a second wash cycle and the addition of 100 μL of substrate/chromogen 3,3’,5,5’-Tetramethylbenzidine (TMB) (Surmodics), the plates were incubated for 5 min at RT in the dark producing a colorimetric reaction (blue indicating positive samples, no color indicating negative ones). The reaction was stopped by adding 100 μL of stop solution (0.2 M sulfuric acid from Agrolabo S.p.A.) and results were interpreted instrumentally by measuring the optical density (OD) at 450 nm using an ELISA microplate reader (Multiskan SkyHigh, Thermo Fisher Scientific). The test was considered valid if the OD value for the PC was above 0.6, and the OD for the NC was below 0.1.
ELISA validation
Since IFAT is generally considered the serological “gold standard” test for detecting exposure to E. canis in dogs [26, 46, 51, 61], EhrlichiaCHECK Ab ELISA was validated by testing 112 canine sera (51 positives and 61 negatives) against the IFAT FLUO Ehrlichia canis kit (Agrolabo S.p.A.), following the manufacturer’s instructions. The IFAT kit consisted of slides coated with canine macrophages infected with E. canis which were observed under a fluorescence microscope equipped with an FITC filter. Samples in which the cells showed no yellow-green fluorescence or appeared greyish-red were classified as negative, while those with bright yellow-green fluorescence and stained inclusion bodies (morulae) in the cytoplasm were considered positive. A sample was considered positive if the first dilution (1:40) showed a positive result.
Comparative analysis
The performance of EhrlichiaCHECK Ab ELISA was assessed by analyzing 51 canine samples (24 positives and 27 negatives) and comparing the results with those from the widely used INgezim Ehrlichia ELISA (Gold Standard Diagnostics, Madrid, Spain) [16, 32]. In all cases, IFAT was considered the reference method. The INgezim Ehrlichia ELISA was performed according to the manufacturer’s instructions.
ELISA accuracy assessment
Precision and accuracy were evaluated by calculating the intra- or inter-assay coefficients of variation (CV), which were obtained within a single run or across different runs, respectively. Positive and negative samples were tested by two operators on different days and at various times, as described in the guidelines [63], with 8 replicates on 3 separate batches for a total of 24 repetitions per sample, in accordance with the International Council for Harmonization (ICH) Q2 (R1) guidance [22]. Test precision was assessed for each sample by calculating the mean, minimum, and maximum optical density (OD) values, standard deviation, and %CV.
ELISA kit shelf-life evaluation
As there are no specific regulations for stability testing of veterinary diagnostic kits, we referred to the Standard Guide for Accelerated Aging of Sterile Medical Device Packages ASTM F1980-21 [3], which applies the Arrhenius equation to estimate the degradation of medical devices under accelerated conditions. The duration of accelerated storage was determined using online calculators [30, 45], corresponding to 6 weeks at +37 °C, which is equivalent to 18 months of real-time stability at +2–8 °C. For both the accelerated and real-time stabilities, the initial test was performed at time zero (T0), followed by assays every 2 weeks for the first 6 weeks. After this period, only kits stored refrigerated at +2–8 °C (real-time conditions) were tested every 3 months up to 18 months. For each sample and control, the percentage of remaining activity (%RA) was calculated as the ratio of the OD value obtained at a specific time to that at time T0, with 70% being the lower limit of acceptability [34]. The number of samples tested was consistent with that used in the literature [41, 66].
ELISA cut-off determination
To enhance the precision of the test, several methods were employed to estimate the ELISA cut-off. In preliminary assays, the cut-off was calculated as the mean OD value of negative samples plus three times the standard deviation (SD) [13, 31, 33]. Samples were classified based on their OD values, 10% above or below the cut-off, as in other commercial ELISA tests [1, 20]. This method and other approaches were used to estimate the cut-off considering 112 samples (51 positive and 61 negative), already utilized in ELISA validation. According to these, the optimal cut-off should correspond to the OD value where the difference between sensitivity and specificity was minimized [38], or as a value between the maximum OD value of negative samples and the minimum OD value of positive samples [33]. Additionally, the optimal cut-off that maximized the difference between true positives and false-positives was estimated using the Receiver Operating Characteristics (ROC) curve and Youden’s index (J), which ranges from 0 (completely ineffective test) to 1.0 (perfectly effective test). Furthermore, the numbers of true positives (a), false-positives (b), false-negatives (c), and true negatives (d) from the comparison of EhrlichiaCHECK Ab ELISA with IFAT were used to calculate diagnostic parameters including accuracy, sensitivity, specificity, positive likelihood ratio (LR+) and negative likelihood ratio (LR−). The 95% confidence interval (CI) was calculated for sensitivity and specificity.
Bioinformatics analysis
Cross-reactions were theoretically investigated through bioinformatics analysis of the two different antigens used in EhrlichiaCHECK Ab ELISA (Agrolabo S.p.A.) and INgezim Ehrlichia ELISA (Gold Standard Diagnostics). The protein sequences were obtained from the National Center for Biotechnology Information (NCBI) database (E. canis p30, GenBank accession number: AAC68667.1; E. canis gp19, GenBank accession number: ABU44523.1) and compared using the Basic Local Alignment Search Tool (BLAST) of NCBI.
Statistical analysis
Statistical analysis was performed for the comparison study using a t-test, with a p-value < 0.05 considered significant. Cohen’s d index was used to measure the strength of the relationship (Effect size: d = 0.2 for small effect, d = 0.5 for moderate effect, d = 0.8 for large effect), and Cohen’s Kappa coefficient index was applied to calculate the degree of agreement beyond chance.
Results
Preliminary setup and conjugate dilution selection
Preliminary assays were conducted on microplates coated with 0.5 μg/mL or 1 μg/mL of E. canis gp19 antigen by testing 16 samples (12 negative and 4 positive) with conjugate antibody dilutions 1:30,000 and 1:40,000. ELISA accurately distinguished negative from positive samples, with OD values falling below or above the cut-off accordingly. Additionally, no significant differences in OD values were observed between the two coating conditions tested with both conjugates (Table 1).
Preliminary ELISA test.
Tests with a longer sample incubation time of 30 minutes performed well and showed no substantial differences in OD values between plates coated with 0.5 μg/mL or 1 μg/mL of E. canis gp19 antigen (Supplementary Table S1). Based on these results, for future experiments, we decided to perform ELISA with a 15-minute sample incubation time on plates coated with 0.5 μg/mL E. canis antigen and using the 1:30,000 conjugate antibody dilution to achieve optimal performance in a faster and more cost-effective manner.
Positive and negative control selection
Since no commercially available antibodies were directed against the plate-immobilized antigen, and the recombinant gp19 antigen contains a histidine tag, anti-histidine antibodies labelled with HRP were tested as positive control (PC). During assay development, three types of anti-His antibodies (PC1, PC2, PC3) and a pool of canine positive sera (PC4) were considered. It is known that a strong positive sample should have an OD value of 1.5 or higher [2, 64], with a minimum OD value of 0.6 for test acceptability, as reported in the literature [2, 64] and in other ELISA tests [50, 57, 59]. Anti-His antibodies (PC1, PC2, and PC3) were tested at dilutions of 1:1000 and 1:8000, but all yielded invalid results, with OD values below the acceptable limit of 0.6. However, the pool of positive canine sera (PC4), tested at dilutions of 1:100, 1:150, and 1:200, yielded good results, with OD values above 0.6 (Table 2).
ELISA positive and negative controls evaluation.
For the negative control (NC), we tested a sample diluent composed of PBS and BSA, as used in other ELISA tests [21, 25, 28, 43, 48]. This NC was tested in 10 replicates, and all OD values were below 0.1, within the acceptable OD limit of 0.3 [2, 64] (Table 2). Additionally, we tested 58 negative samples diluted 1:100 to ensure their signal was similar to that of the new NC. In this case, the results were also satisfactory, with OD values below 0.1 and the mean OD value within the range defined by the standard deviation of the negative samples, which supports the use of the sample diluent as the NC.
Estimation of ELISA cut-off value
The detailed results obtained for the 112 samples (51 IFAT-positive and 61 IFAT-negative) used for the cut-off estimation and kit validation are described in Supplementary Table S2. The preliminary cut-off was confirmed using several methods. According to literature reports, the cut-off for the new ELISA should fall between the maximum OD value of negative samples (OD 0.275) and the minimum OD value of positive samples (OD 0.375) [33], or around an OD value of 0.280, representing the point where the difference between sensitivity and specificity is minimal (difference of 0.010) [38]. At the OD cut-off of 0.280, sensitivity and specificity were 96.1% and 95.1%, respectively. These parameters remained stable up to an OD cut-off of 0.370 (Supplementary Table S3). Finally, both the ROC curve (Figure 1) and Youden’s index indicated that the optimal cut-off was at an OD value of 0.280 (maximum J value: 0.912) (Figure 2). Although the precise cut-off for EhrlichiaCHECK Ab ELISA was OD 0.280, since sensitivity and specificity remained unchanged up to OD 0.370, we selected an OD value of 0.300 as the final cut-off for the kit, with a 10% uncertainty level corresponding to the “doubtful zone”.
 |
Figure 1 Cut-off determination by ROC curve. The graph visualizes the diagnostic ability of a test by plotting the true positive rate (sensitivity) against the false positive rate (1 – specificity) at various threshold settings. The upper left point in the curve corresponds to the best cut-off. In our case, sensitivity was 0.961 (96.1%) and the false-positive rate was 0.049 (low probability, 4.9%). |
 |
Figure 2 Cut-off determination by Youden’s index. The maximum value of Youden’s index represented the best test cut-off value and corresponded to 0.912. This value is maintained from cut-off number (N. Cut-off) 26 to 35. |
EhrlichiaCHECK Ab ELISA validation
The EhrlichiaCHECK Ab ELISA was validated against the IFAT, which was used as the reference method, utilizing the same samples previously used for cut-off determination (Supplementary Table S2). Figure 3 and Figure 4 show examples of both negative and positive results, respectively, obtained using IFAT. The ELISA cut-off was calculated as described earlier and set at OD 0.300. The new assay identified 52 positives (compared to 51 by IFAT) and 60 negatives (compared to 61 by IFAT), resulting in three false-positives and two false-negatives (Table 3, Supplementary Table S2). Compared to IFAT, the EhrlichiaCHECK Ab ELISA demonstrated 95.5% agreement, with sensitivity of 96.1% (95% CI: 85.4%–99.3%) and specificity of 95.1% (95% CI: 85.4%–98.7%). Cohen’s Kappa coefficient was 0.904, indicating very good agreement. The test accuracy was 100%, the negative likelihood ratio (LR−) was 0.041, and the positive likelihood ratio (LR+) was 19.536.
 |
Figure 3 Example of IFAT-negative result obtained on a negative sample observed at 100× by using the IFAT kit FLUO Ehrlichia canis (Agrolabo S.p.A.). |
 |
Figure 4 Example of IFAT-positive result obtained on a positive sample observed at 100× by using the IFAT kit FLUO Ehrlichia canis (Agrolabo S.p.A.). |
Validation results of EhrlichiaCHECK Ab ELISA against IFAT (reference test).
Reproducibility and precision assessment
The accuracy of the EhrlichiaCHECK Ab ELISA was evaluated by testing controls, two positive samples, and two negative samples in 8 replicates across 3 batches, totaling 24 repetitions for each sample. Detailed results are provided in Supplementary Table S4. The EhrlichiaCHECK Ab ELISA exhibited high accuracy, with both intra- and inter-assay coefficients of variation (%CV) remaining within the acceptable 20% limit [15] (Table 4).
Reproducibility and intra- and inter-assay coefficients of variation.
Comparison study with commercial kit
The performance of the EhrlichiaCHECK Ab ELISA was compared to the commercially available INgezim Ehrlichia ELISA (Gold Standard Diagnostics) by analyzing 51 canine samples (24 positives and 27 negatives). The new test showed agreement of 98.0% with the INgezim Ehrlichia ELISA (Cohen’s Kappa: 0.961, indicating very good agreement) (Table 5). Overall, we obtained good results for both positive and negative samples, with one false-positive observed in the INgezim Ehrlichia ELISA (sample n = 11, OD value 2.604) (Supplementary Table S5). Table 6 shows a comparison of both ELISA methods against IFAT (reference method). Agreement with the first assay was 100% (100% sensitivity, 95% CI: 82.8%–100%; 100% specificity, 95% CI: 84.5%–100%; Cohen’s Kappa: 1.000), while the agreement with the second assay was 98.0% (100% sensitivity, 95% CI: 82.8%–100%; 96.3% specificity, 95% CI: 79.1%–99.8%; Cohen’s Kappa: 0.961). Thus, the EhrlichiaCHECK Ab ELISA demonstrated higher specificity compared to the INgezim Ehrlichia ELISA.
Comparison results of EhrlichiaCHECK Ab ELISA (Agrolabo) against the INgezim Ehrlichia ELISA (Gold Standard Diagnostics).
Comparison results of EhrlichiaCHECK Ab ELISA (Agrolabo) and INgezim Ehrlichia ELISA (Gold Standard Diagnostics) against IFAT.
Additionally, statistical analysis using a t-test (p-value < 0.05) comparing the mean OD values of the two assays revealed that both the POSITIVE and negative OD values in the EhrlichiaCHECK Ab ELISA were statistically significantly lower than those in the INgezim Ehrlichia ELISA. However, the effect sizes, calculated using Cohen’s d index, were 1.113 for negative samples (indicating a large difference) and 0.080 for positive samples (indicating a small difference) (data not shown).
Cross-reaction evaluation by bioinformatics analysis
It is known that the INgezim Ehrlichia ELISA uses the recombinant p30 protein of E. canis [36], while our EhrlichiaCHECK Ab ELISA employs the E. canis gp19 antigen. Since Ehrlichia spp. share similar antigenic molecules [61], we performed a bioinformatics analysis to theoretically assess potential cross-reactions, which may explain the differences in sensitivity and specificity observed between the two ELISA kits. We applied the commonly accepted criterion that two sequences are homologous if they are more than 30% identical over their entire lengths [47].
From the analysis of the E. canis p30 protein, we found that it shares significant similarity with many other Ehrlichia spp. antigens. Specifically, high similarity (greater than 60%) was observed with the P44/Msp2 family outer membrane protein (OMP) in E. canis, Ehrlichia minasensis, Ehrlichia muris, Ehrlichia japonica, E. chaffeensis, and Ehrlichia ruminantium; the surface antigen Msp4 of E. minasensis; the P28 antigen of E. chaffeensis, E. canis, and E. muris; OMP-1 of Ehrlichia ewingii; p30-1 and p30-2 of E. canis; and Major Antigenic Protein 1 (Map1) of E. ruminantium (Table 7). In contrast, we found that the E. canis gp19 antigen shares similarity with the P13 protein of E. muris (greater than 40%) and with the “hypothetical protein” of E. minasensis (greater than 50%), E. muris, and E. japonica (greater than 40%) (Table 7). These “hypothetical proteins” are now identified as TRP proteins, including TRP19 (or gp19) [37].
Similarity research through bioinformatics analysis on E. canis p30 and gp19 antigens.
Estimation of ELISA test expiry
During all analytical sessions conducted in the accelerated stability study at +37 °C for 6 weeks, both samples and controls showed a percentage of remaining activity (% RA) consistently above 70% (Supplementary Table S6). These results were further confirmed in the long-term stability study (data not shown).
Discussion
CME is the most severe form of canine ehrlichiosis and is found worldwide. Three major immunoreactive tandem repeat proteins (TRPs) including TRP19, TRP36, and TRP140 have been identified as key markers for diagnosing E. canis infection. Among these, the highly conserved protein TRP19 (also known as gp19) is the most reliable and preferred for the immunodiagnosis of CME [37, 46]. In this study, we present the new EhrlichiaCHECK Ab ELISA, which is based on the gp19 antigen of E. canis and developed with IFAT as the gold standard method [26, 46, 51, 61]. The new ELISA demonstrated excellent agreement with IFAT, showing 95.5% concordance, with sensitivity of 96.1% (95% CI: 85.4%–99.3%) and specificity of 95.1% (95% CI: 85.4%–98.7%). It can be conducted at RT without the need for specialized laboratory equipment, requiring only an ELISA microplate reader for result interpretation. Furthermore, the assay exhibited high accuracy, with both intra- and inter-assay %CVs within the acceptable limits [15, 34].
Since an anti-gp19 antibody was not commercially available at the time of test development, we explored the use of anti-histidine antibodies as positive controls (PCs) as an alternative to canine samples. It is well-known that histidine tags are commonly used as affinity tags for purifying recombinant proteins [8] and for their detection by antibodies [18, 27, 35, 65]. Unfortunately, the three anti-His antibodies tested produced invalid results, with OD values below the acceptable limit of 0.6. In contrast, only the pool of canine positive sera proved to be an effective PC. We hypothesize that during the coating process, the antigen likely folds in a way that prevents the exposure of the histidine tail, thus not allowing recognition by the anti-histidine antibodies. Unlike the PC, which worked only with positive samples, the NC formed by sample diluent, rather than negative specimens, proved valuable. The mean OD of the NC was consistently below 0.1, well within the OD limit of 0.3 and aligned with the values obtained from negative samples. Notably, PBS-based solutions are already used as NCs in ELISA tests designed for both scientific purposes and commercially available assays [21, 25, 28, 43, 48].
We demonstrated the absence of non-specific binding to the coating constituents by analyzing both controls and samples. However, potential interference from substances in the blood, such as pharmaceuticals or naturally occurring compounds linked to inflammation, should be considered. We have not conducted in-depth studies to determine cross-reactivity reactions, in part due to the challenges in obtaining representative samples.
A positive result from ELISA or IFAT only indicates past or present infection and does not necessarily reflect the current disease status [4]. During the ELISA validation process, three false-positive and two false-negative results were detected. Since Ehrlichia spp., particularly those within the same genogroup, share similar antigenic molecules, serological tests may be affected by cross-reactions. It is known that IFAT can be influenced by cross-reactivity between E. canis and E. chaffeensis due to shared OMP proteins such as p30, p30-1, and p30a [44, 61]. As partially confirmed by our bioinformatics analysis, these proteins exhibit significant similarity to those in the OMP-1 gene family of E. chaffeensis [44] and the major antigen protein 1 (MAP-1) of E. ruminantium [60]. Additionally, E. muris may cross-react serologically with E. chaffeensis and E. canis [62]. Notably, a cross-reaction has also been observed between the p30 antigen of E. canis and seropositive Leishmania infantum samples [36]. Moreover, canine sera from E. ewingii, known to induce the granulocytic ehrlichiosis in dogs and tested against E. canis antigens showed binding patterns similar to those of anti-E. canis sera [54, 61]. Cross-reactions have also been documented between E. canis and species within the E. phagocytophila genogroup, as well as with Neorickettsia helminthoeca, the causative agent of salmon poisoning disease [53, 61]. When interpreting results, it is essential to consider the geographic area of residence and the history of the suspected dog.
The performance of the EhrlichiaCHECK Ab ELISA was evaluated against the INgezim Ehrlichia ELISA, which uses the recombinant E. canis p30 protein [36]. The INgezim Ehrlichia ELISA showed 98.0% agreement with our ELISA and, when compared to IFAT, demonstrated sensitivity of 100% and specificity of 96.3%. In contrast, our ELISA, based on the E. canis gp19 antigen, exhibited both 100% sensitivity and 100% specificity. We identified one false-positive result with the INgezim Ehrlichia ELISA, which could be explained by the antigen used in the assay. In this context, we assessed potential cross-reactions through bioinformatics analysis of the p30 and gp19 proteins of E. canis. Based on the general rule according to which two sequences are considered homologous if they share more than 30% identity in length [47], we found that the p30 protein is similar to several other Ehrlichia spp. antigens, including the P44/Msp2 family outer membrane protein, surface antigen msp4, p28 antigen, OMP-1, p30-1, p30-2, and MAP1 proteins of E. canis, E. minasensis, E. muris, E. japonica, E. chaffeensis, E. ruminantium, and E. ewingii. In contrast, the E. canis gp19 antigen exhibited a narrower cross-reactivity spectrum, reacting only with other TRP19 homologous proteins from E. minasensis, E. muris, and E. japonica, as well as with the E. muris P13 ortholog protein [37, 58]. Additionally, TRP19 did not cross-react with antibodies in sera from dogs infected with E. chaffeensis, thereby providing species-specific discrimination between E. canis and E. chaffeensis infections [12]. This evidence may explain why the EhrlichiaCHECK Ab ELISA was more specific than the INgezim Ehrlichia ELISA.
Furthermore, false-negative results may occur in immunocompromised patients in which antibody concentrations below the lower detection limit of the assay could lead to negative results. Additionally, an animal may be serologically negative during the early stages of the disease or within the incubation period [4]. False-positives and false-negatives should be retested and, in any case, confirmed with another test. Diagnosing ehrlichiosis is complex, and the presence of antibodies to E. canis must be interpreted in conjunction with other diagnostic findings, such as disease progression, cross-reactivity with other Ehrlichia spp., and potential co-infections with other tick-borne diseases to reach a final diagnosis of CME.
Moreover, the earliest antibody response against E. canis is typically detected between 14 and 21 days post-infection, primarily targeting the gp36 and gp19 proteins [26, 39]. The gp19 protein is highly conserved among E. canis strains and can be detected in dog sera early during the acute phase of CME [39, 42]. As previously reported, ELISA tests based on the recombinant glycoproteins TRP36 (gp36) and TRP19 (gp19) have shown enhanced sensitivities compared to IFAT. In fact, antibodies against E. canis were detected on day 14 post-inoculation, up to 2 weeks earlier than with IFAT [12].
Stability tests were conducted at specific temperatures that reflect the climatic conditions of the regions where the product will be marketed [5, 40]. Once the product proves stable under storage conditions simulating a warmer climate, it is automatically considered suitable for use in colder areas. Accelerated stability studies are typically carried out at +37 °C, as this is the most effective method for speeding up the product’s degradation reactions, enabling a quick determination of its shelf life, rather than waiting for prolonged natural deterioration [10, 11]. Numerous accidental events, such as interruptions in the cold chain, may occur during shipping or storage and can negatively affect product’s quality and effectiveness. Unlike pharmaceutical products or veterinary drugs for which specific guidelines for stability testing are available [14, 24], there are no established regulations governing the shelf life of veterinary diagnostic kits. Stability studies conducted in accordance with the Standard Guide for Accelerated Aging of Sterile Medical Device Packages, ASTM F1980-21 [3] demonstrated that the kit remained stable for 6 weeks at +37 °C and for 18 months at the normal storage temperature of +2–8 °C.
Conclusions
Since CME may be fatal if not treated and rapid diagnosis is needed, the new EhrlichiaCHECK Ab ELISA developed by Agrolabo S.p.A. is able to provide fast and accurate results about the presence or absence of anti-E. canis antibodies in approximately 35 min. It is sensitive and easy to perform, and may be more specific than other commercialized assays because it is based on a new antigen that limits cross-reactivities towards other Ehrlichia spp. In conclusion, the new kit may be a valuable tool for confirming exposure to E. canis in settings where more advanced techniques, such as IFAT, Western blotting, PCR, and tissue culture are not readily available.
Acknowledgments
The authors express their gratitude to all participants who agreed to take part in the project. Special thanks are extended to the veterinary practices and clinics in Italy (Veterinary Center of Lungo Dora Colletta, Turin; Veterinary Center Dr. Vassia of Romano Canavese, Turin; Piazza D’Armi Veterinary Center, Turin; Veterinary Center “Amici per sempre”, Rome) and in Greece (Attica region) for their help with specimen collection.
Funding
This research received no external funding.
Conflicts of interest
Authors Irene Ferrero, Paolo Poletti, and Enrica Giachino were employed by the company Agrolabo S.p.A. The remaining authors declare that the research was conducted in the absence of any commercial or financial relationships that could be construed as a potential conflict of interest.
Data availability statement
Data are available in this published article and as supplementary information. Datasets generated during the current study are also available from the corresponding author on reasonable request.
Author contribution statement
IF, PP and EG: conceptualization, methodology, software, validation; formal analysis, investigation, resources, data curation; writing – original draft preparation; JF and PDA: writing-review, editing, visualization, supervision. All authors have read and agreed to the published version of the manuscript.
Supplementary material
Supplementary Table S1. ELISA results after sample incubation time of 30 min. Access Supplementary Material
Supplementary Table S2. EhrlichiaCHECK Ab ELISA validation against IFAT. Access Supplementary Material
Supplementary Table S3. Analysis for cut-off determination. Access Supplementary Material
Supplementary Table S4. Detailed ELISA results obtained during reproducibility study. Access Supplementary Material
Supplementary Table S5. Comparison between EhrlichiaCHECK Ab ELISA (Agrolabo) and INgezim Ehrlichia ELISA (Gold Standard Diagnostics). Access Supplementary Material
Supplementary Table S6. Accelerated stability study. Access Supplementary Material
References
- Antibodies online. Syphilis IgM antibody ELISA kit (ABIN997000). Available at https://www.antibodies-online.com/kit/997000/Syphilis+IgM+Antibody+ELISA+Kit/ (accessed on 4 April 2023). [Google Scholar]
- Appeltrath GA, Parreuter J, Lindemann M, Klump H, Karsten CB. 2024. An efficient ELISA protocol for measurement of SARS-CoV-2 spike-specific IgG in human plasma and serum samples. MethodsX, 12, 102596. [Google Scholar]
- ASTM International. 2021. ASTM F1980-21: standard for accelerated aging of sterile barrier systems and medical devices. Pennsylvania, USA: ASTM International. [Google Scholar]
- Aziz MU, Hussain S, Song B, Ghauri HN, Zeb J, Sparagano OA. 2022. Ehrlichiosis in dogs: a comprehensive review about the pathogen and its vectors with emphasis on south and east Asian countries. Veterinary Sciences, 10, 21. [Google Scholar]
- Bajaj S, Singla D, Sakhuja N. 2012. Stability testing of pharmaceutical products. Journal of Applied Pharmaceutical Science, 2, 129–138. [Google Scholar]
- Biomol GmbH, Bethyl Laboratories Inc. ELISA protocol. Available at https://www.biomol.com/dateien/Bethyl–ELISA-Protocol.pdf (accessed on 13 September 2022). [Google Scholar]
- Boonhoh W, Sontigun N, Fungwithaya P, Wongtawan T. 2023. Hematological analysis of naturally infecting blood parasites in dogs. Veterinary World, 16, 681–686. [Google Scholar]
- Bornhorst JA, Falke JJ. 2000. Purification of proteins using polyhistidine affinity tags. Methods in Enzymology, 326, 245–254. [Google Scholar]
- Breitschwerdt EB, Hegarty BC, Hancock SI. 1998. Sequential evaluation of dogs naturally infected with Ehrlichia canis, Ehrlichia chaffeensis, Ehrlichia equi, Ehrlichia ewingii, or Bartonella vinsonii. Journal of Clinical Microbiology, 36, 2645–2651. [Google Scholar]
- Campa C, Pronce T, Paludi M, Weusten J, Conway L, Savery J, Richards C, Clénet D. 2021. Use of stability modeling to support accelerated vaccine development and supply. Vaccines, 9, 1114. [Google Scholar]
- Cannell JS. 1985. Fundamentals of stability testing. International Journal of Cosmetic Science, 7, 291–303. [Google Scholar]
- Cárdenas AM, Doyle CK, Zhang X, Nethery K, Corstvet RE, Walker DH, McBride JW. 2006. Enzyme-Linked Immunosorbent Assay with conserved immunoreactive glycoproteins gp36 and gp19 has enhanced sensitivity and provides species-specific immunodiagnosis of Ehrlichia canis infection. Clinical and Vaccine Immunology, 14, 123–128. [Google Scholar]
- Chen R, Shang H, Niu X, Huang J, Miao Y, Sha Z, Liting Q, Huang H, Peng D, Zhu R. 2021. Establishment and evaluation of an indirect ELISA for detection of antibodies to goat Klebsiella pneumonia. BMC Veterinary Research, 17, 107. [Google Scholar]
- Committee for Veterinary Medicinal Products (CVMP). 2024. Guideline on stability testing for applications for variations to a marketing authorisation for veterinary medicinal product (EMA/CVMP/QWP/515653/2023). Amsterdam, The Netherlands: European Medicine Agency (EMA). [Google Scholar]
- Conrad B. 2023. %CV in ELISA: How to reduce them and why they’re important. Enzo Biochem Inc. Available at https://www.enzo.com/note/cv-in-elisa-how-to-reduce-them-and-why-theyre-important/ (accessed on 18 January 2023). [Google Scholar]
- Cortadellas O, Fernández-del Palacio MJ, Talavera J, Bayón A. 2009. Serum phosphorus concentrations in dogs with leishmaniosis at different stages of chronic kidney disease. Veterinary Record, 164, 487–490. [Google Scholar]
- Cusabio Tachnology. ELISA protocols. Available at https://www.cusabio.com/protocols/ELISA_Protocol.pdf (accessed on 25 October 2022). [Google Scholar]
- Debeljak N, Feldman L, Davis KL, Komel R, Sytkowski AJ. 2006. Variability in the immunodetection of his-tagged recombinant proteins. Analytical Biochemistry, 359, 216–223. [Google Scholar]
- Deutschmann C, Roggenbuck D, Schierack P, Rodiger S. 2020. Autoantibody testing by enzyme-linked immunosorbent assay-a case in which the solid phase decides on success and failure. Helicon, 6, e03270. [Google Scholar]
- DRG Instruments GmbH. Instructions for use. Rubella IgM ELISA (Ref: EIA-3511). Available at https://www.sceti.co.jp/images/psearch/pdf/DRG_EIA3511_p.pdf (accessed on 27 March 2023). [Google Scholar]
- European Monoclonal Antibodies Network (EuroMAbNet). ELISA Protocol. Available at https://www.euromabnet.com/protocols/elisa.php (accessed on 23 February 2023). [Google Scholar]
- Food and Drug Administration (FDA). 2021. Q2(R1) Validation of analytical procedures: text and methodology. Guidance for industry. Silver Spring, Maryland, USA: US FDA. [Google Scholar]
- GeneTex. Protocol: Indirect ELISA. Available at https://www.genetex.com/upload/media/support/protocols/genetex_ELISA(indirect).pdf (accessed on 16 December 2022). [Google Scholar]
- González-González O, Ramirez IO, Ramirez BI, O’Connell P, Ballesteros MP, Torrado JJ, Serrano DR. 2022. Drug stability: ICH versus accelerated predictive stability studies. Pharmaceutics, 14, 2324. [Google Scholar]
- Hagler JR, Naranjo SE. 1994. Determining the frequency of heteropteran predation on sweetpotato whitefly and pink bollworm using multiple ELISAs. Entomologia Experimentalis et Applicata, 72, 59–66. [Google Scholar]
- Harrus S, Waner T. 2011. Diagnosis of canine monocytotropic ehrlichiosis (Ehrlichia canis): an overview. Veterinary Journal, 187, 292–296. [Google Scholar]
- He S, Xu R, Yi H, Chen Z, Chen C, Li Q, Han Q, Xia X, Song Y, Xu J, Zhang J. 2022. Development of alkaline phosphatase-scFv and its use for one-step enzyme-linked immunosorbent assay for his-tagged protein detection. Open Life Sciences, 17, 1505–1514. [Google Scholar]
- ImmunoReagents Inc. A general protocol on how to conduct an ELISA assay. Available at https://www.immunoreagents.com/protocols/view/2 (accessed on 28 February 2023). [Google Scholar]
- Keysary A, Waner T, Rosner M, Warner CK, Dawson JE, Zass R, Biggie KL, Harrus S. 1996. The first isolation, in vitro propagation, and genetic characterization of Ehrlichia canis in Israel. Veterinary Parasitology, 62, 331–340. [Google Scholar]
- Keystone Compliance. Accelerated aging time calculator. Available at https://keystonecompliance.com/aat-calculator/ (accessed on 13 December 2019). [Google Scholar]
- Khatri S, Psaraftis N, Funaro A, Arinuma Y, Fujieda Y, Mader S, Jørgensen CD, Astakhova K. 2020. Serological comparison of systemic lupus erythematosus with neuropsychiatric lupus using synthetic nucleic acid antigens. Journal of Translational Autoimmunity, 3, 100068. [Google Scholar]
- Kostopoulou D, Gizzarelli M, Ligda P, Manzillo VF, Saratsi K, Montagnaro S, Schunack B, Boegel A, Pollmeier M, Oliva G, Sotiraki S .2020. Mapping the canine vector-borne disease risk in a Mediterranean area. Parasites & Vectors, 13, 282. [Google Scholar]
- Lardeux F, Torrico G, Aliaga C. 2016. Calculation of the ELISA’s cut-off based on the change-point analysis method for detection of Trypanosoma cruzi infection in Bolivian dogs in the absence of controls. Memórias do Instituto Oswaldo Cruz, 111, 501–504. [Google Scholar]
- Lexmond W, van der Mee J, Ruiter F, Platzer B, Stary G, Yen EH, Dehlink E, Nurko S, Fiebiger E. 2011. Development and validation of a standardized ELISA for the detection of soluble Fc-epsilon-RI in human serum. Journal of Immunological Methods, 373, 192–199. [Google Scholar]
- Lindner P, Bauer K, Krebber A, Nieba L, Kremmer E, Krebber C, Honegger A, Klinger B, Mocikat R, Plückthun A. 1997. Specific detection of his-tagged proteins with recombinant anti-His tag scFv-Phosphatase or scFv-Phage fusions. BioTechniques, 22, 140–149. [Google Scholar]
- López L, Venteo A, Aguirre A, García M, Rodríguez M, Amusátegui I, Tesouro MA, Vela C, Sainz A, Rueda P. 2007. Development of a sensitive and specific indirect enzyme-linked immunosorbent assay based on a baculovirus recombinant antigen for detection of specific antibodies against Ehrlichia canis. Journal of Veterinary Diagnostic Investigation, 19, 635–642. [Google Scholar]
- Luo T, Patel JG, Zhang X, Walker DH, McBride JW. 2020. Ehrlichia chaffeensis and E. canis hypothetical protein immunoanalysis reveals small secreted immunodominant proteins and conformation-dependent antibody epitopes. NPJ Vaccines, 5, 85. [Google Scholar]
- Mazzu-Nascimento T, Morbioli GG, Milan LA, Silva DF, Donofrio FC, Mestrinerg CA, Carrilho E. 2017. Improved assessment of accuracy and performance indicators in paper-based ELISA. Analytical Methods, 9, 2644–2653. [Google Scholar]
- McBride JW, Doyle CK, Zhang X, Cardenas AM, Popov VL, Nethery KA, Woods ME. 2007. Identification of a glycosylated Ehrlichia canis 19-Kilodalton major immunoreactive protein with a species-specific serine-rich glycopeptide epitope. Infection and Immunity, 75, 74–82. [Google Scholar]
- Mechkovski A. 1994. WHO guidelines on stability testing of pharmaceutical products containing well-established drug substances in conventional dosage forms. Geneva, Switzerland: World Health Organization (WHO). [Google Scholar]
- Mei L, Wu P, Ye J, Gao G, Shao L, Huang S, Yaoming L, Xiaohong Y, Huanchun C, Shengbo C. 2012. Development and application of an antigen capture ELISA assay for diagnosis of Japanese encephalitis virus in swine, human and mosquito. Virology Journal, 9, 4. [Google Scholar]
- Nambooppha B, Rittipornlertrak A, Muenthaisong A, Koonyosying P, Chomjit P, Sangkakam K, Tangtrongsup S, Tiwananthagorn S, Sthitmatee N. 2022. Recombinant Ehrlichia canis GP19 protein as a promising vaccine prototype providing a protective immune response in a mouse model. Veterinary Sciences, 9, 386. [Google Scholar]
- Niedrig M, Lademann M, Emmerich P, Lafrenz M. 1999. Assessment of IgG antibodies against yellow fever virus after vaccination with 17D by different assays: neutralization test, haemagglutination inhibition test, immunofluorescence assay and ELISA. Tropical Medicine & International Health, 4, 867–871. [Google Scholar]
- Ohashi N, Zhi N, Zhang Y, Rikihisa Y. 1998. Immunodominant major outer membrane proteins of Ehrlichia chaffeensis are encoded by a polymorphic multigene family. Infection and Immunity, 66, 132–139. [Google Scholar]
- Packaging Compliance Labs. Accelerated aging calculator. Available at https://pkgcompliance.com/resource/accelerated-aging-calculator/ (accessed on 9 January 2024). [Google Scholar]
- Patel JG, Luo T, Zhang X, McBride JW. 2024. Immuno- and expression analysis of Ehrlichia canis immunoreactive proteins. Frontiers in Veterinary Science, 11, 1481934. [Google Scholar]
- Pearson WR. 2013. An introduction to sequence similarity (“homology”) searching. Current Protocols in Bioinformatics, 42, 3.1.1–3.1.8. [Google Scholar]
- Peng J, Song S, Xu L, Ma W, Liu L, Kuang H, Xu C. 2013. Development of a monoclonal antibody-based sandwich ELISA for peanut allergen Ara h 1 in food. International Journal of Environmental Research, 10, 2897–2905. [Google Scholar]
- Piepers S, Jansen MD, Cats EA, van Sorge NM, van den Berg LH, van der Pol WL. 2010. VIg inhibits classical pathway activity and anti-GM1 IgM-mediated complement deposition in MMN. Journal of Neuroimmunology, 229, 256–262. [Google Scholar]
- Raditic DM, Remillard RL, Tater KC. 2011. ELISA testing for common food antigens in four dry dog foods used in dietary elimination trials. Journal of Animal Physiology and Animal Nutrition, 95, 90–97. [Google Scholar]
- Rajagopall A, Basith SA, Gomathinayagam S, Dhinakarraj G. 2009. Evaluation of PCR and IFAT in the diagnosis of canine ehrlichiosis. Journal of Applied Animal Research, 35, 189–191. [Google Scholar]
- Righi C, Iscaro C, Ferroni L, Rosati S, Pellegrini C, Nogarol C, Rossi E, Dettori A, Feliziani F, Petrini S. 2022. Validation of a commercial indirect ELISA kit for the detection of bovine alphaherpesvirus 1 (BoHV-1)-specific glycoprotein E antibodies in bulk milk samples of dairy cows. Veterinary Sciences, 9, 311. [Google Scholar]
- Rikihisa Y. 1991. Cross-reacting antigens between Neorickettsia helminthoeca and Ehrlichia species, shown by immunofluorescence and western immunoblotting. Journal of Clinical Microbiology, 29, 2024–2029. [Google Scholar]
- Rikihisa Y, Ewing SA, Fox JC, Siregar AG, Pasaribu FH, Malole MB. 1992. Analyses of Ehrlichia canis and a canine granulocytic ehrlichia infection. Journal of Clinical Microbiology, 30, 143–148. [Google Scholar]
- Rusanen J, Kareinen L, Levanov L, Mero S, Pakkanen SH, Kantele A, Amanat F, Krammer F, Hedman K, Vapalahti O, Hepojoki J. 2021. A 10-minute “mix and read” antibody assay for SARS-CoV-2. Viruses, 13, 143. [Google Scholar]
- Sgroi G, D’Alessio N, Veneziano V, Rofrano G, Fusco G, Carbonara M, Dantas-Torres F, Otranto D, Iatta R. 2024. Ehrlichia canis in human and tick, Italy, 2023. Emerging Infectious Diseases, 30, 2651–2654. [Google Scholar]
- Sirikajornpan K, Suntarattiwong P, Suwanpakdee D, Tabprasit S, Buddhari D, Thaisomboonsuk B, Klungthong C, Poolpanichupatam Y, Buathong R, Srikiatkhachorn A, Jones A, Fernandez S, Hunsawong T. 2021. Standardization and evaluation of an anti-ZIKV IgM ELISA Assay for the serological diagnosis of Zika virus infection. American Journal of Tropical Medicine and Hygiene, 105, 936–941. [Google Scholar]
- Thirumalapura N, Crocquet-Valdes P, Saito T, Dadfarnia T, DiCicco B, Walker D. 2013. Recombinant Ehrlichia P29 protein, but not P13 protein, induces a protective immune response in a mouse model of ehrlichiosis (P4280). Vaccine, 31, 5960–5967. [Google Scholar]
- Valero MA, Periago MV, Pérez-Crespo I, Rodríguez E, Perteguer MJ, Gárate T, González-Barberá EM, Mas-Coma S. 2012. Assessing the validity of an ELISA test for the serological diagnosis of human fascioliasis in different epidemiological situations. Tropical Medicine & International Health, 17, 630–636. [Google Scholar]
- van Vliet AHM, Jongejan F, van Kleef M, van der Zeijst BAM. 1994. Molecular-cloning, sequence-analysis, and expression of the gene encoding the immunodominant 32 kDa protein of Cowdria ruminantium. Infection and Immunity, 62, 1451–1456. [Google Scholar]
- Waner T, Harrus S, Jongejan F, Bark H, Keysary A, Cornelissen AW. 2001. Significance of serological testing for ehrlichial diseases in dogs with special emphasis on the diagnosis of canine monocytic ehrlichiosis caused by Ehrlichia canis. Veterinary Parasitology, 95, 1–15. [Google Scholar]
- Wen B, Rikihisa Y, Mott J, Fuerst PA, Kawahara M, Suto C. 1995. Ehrlichia muris sp. nov., identified on the basis of 16S rRNA base sequences and serological, morphological, and biological characteristics. International Journal of Systematic and Evolutionary Microbiology, 45, 250–254. [Google Scholar]
- World Organisation for Animal Health (WOAH). 2023. Chapter 1.1.6 – Principles and methods of validation of diagnostic assays for infectious diseases, in: Terrestrial Manual, 12th ed. World Organisation for Animal Health (WOAH): Paris, France. p. 1–27. [Google Scholar]
- Yuan F, Chen C, Covaleda LM, Martins M, Reinhart JM, Sullivan DR, Diel DG, Fang Y. 2023. Development of monoclonal antibody-based blocking ELISA for detecting SARS-CoV-2 exposure in animals. mSphere, 8, e0006723. [Google Scholar]
- Zentgraf H, Frey M, Schwinn S, Tessmer C, Willemann B, Samstag Y, Velhagen I. 1995. Detection of histidine-tagged fusion proteins by using a high-specific mouse monoclonal anti-histidine tag antibody. Nucleic Acids Research, 23, 3347–3348. [Google Scholar]
- Zheng Z, Houchins D, Ung J, Richard JL. 2003. Validation of an ELISA test kit for the detection of deoxynivalenol in several food commodities. JSM Mycotoxins, 2003, 295–302. [Google Scholar]
Cite this article as: Ferrero I, Poletti P, Giachino E, Dall’Ara P & Filipe J. 2025. Evaluation of a newly developed rapid ELISA to detect anti-Ehrlichia canis antibodies in dogs. Parasite 32, 62. https://doi.org/10.1051/parasite/2025054.
All Tables
Comparison results of EhrlichiaCHECK Ab ELISA (Agrolabo) against the INgezim Ehrlichia ELISA (Gold Standard Diagnostics).
Comparison results of EhrlichiaCHECK Ab ELISA (Agrolabo) and INgezim Ehrlichia ELISA (Gold Standard Diagnostics) against IFAT.
Similarity research through bioinformatics analysis on E. canis p30 and gp19 antigens.
All Figures
 |
Figure 1 Cut-off determination by ROC curve. The graph visualizes the diagnostic ability of a test by plotting the true positive rate (sensitivity) against the false positive rate (1 – specificity) at various threshold settings. The upper left point in the curve corresponds to the best cut-off. In our case, sensitivity was 0.961 (96.1%) and the false-positive rate was 0.049 (low probability, 4.9%). |
| In the text | |
 |
Figure 2 Cut-off determination by Youden’s index. The maximum value of Youden’s index represented the best test cut-off value and corresponded to 0.912. This value is maintained from cut-off number (N. Cut-off) 26 to 35. |
| In the text | |
|
Figure 3 Example of IFAT-negative result obtained on a negative sample observed at 100× by using the IFAT kit FLUO Ehrlichia canis (Agrolabo S.p.A.). |
| In the text | |
 |
Figure 4 Example of IFAT-positive result obtained on a positive sample observed at 100× by using the IFAT kit FLUO Ehrlichia canis (Agrolabo S.p.A.). |
| In the text | |
Current usage metrics show cumulative count of Article Views (full-text article views including HTML views, PDF and ePub downloads, according to the available data) and Abstracts Views on Vision4Press platform.
Data correspond to usage on the plateform after 2015. The current usage metrics is available 48-96 hours after online publication and is updated daily on week days.
Initial download of the metrics may take a while.


